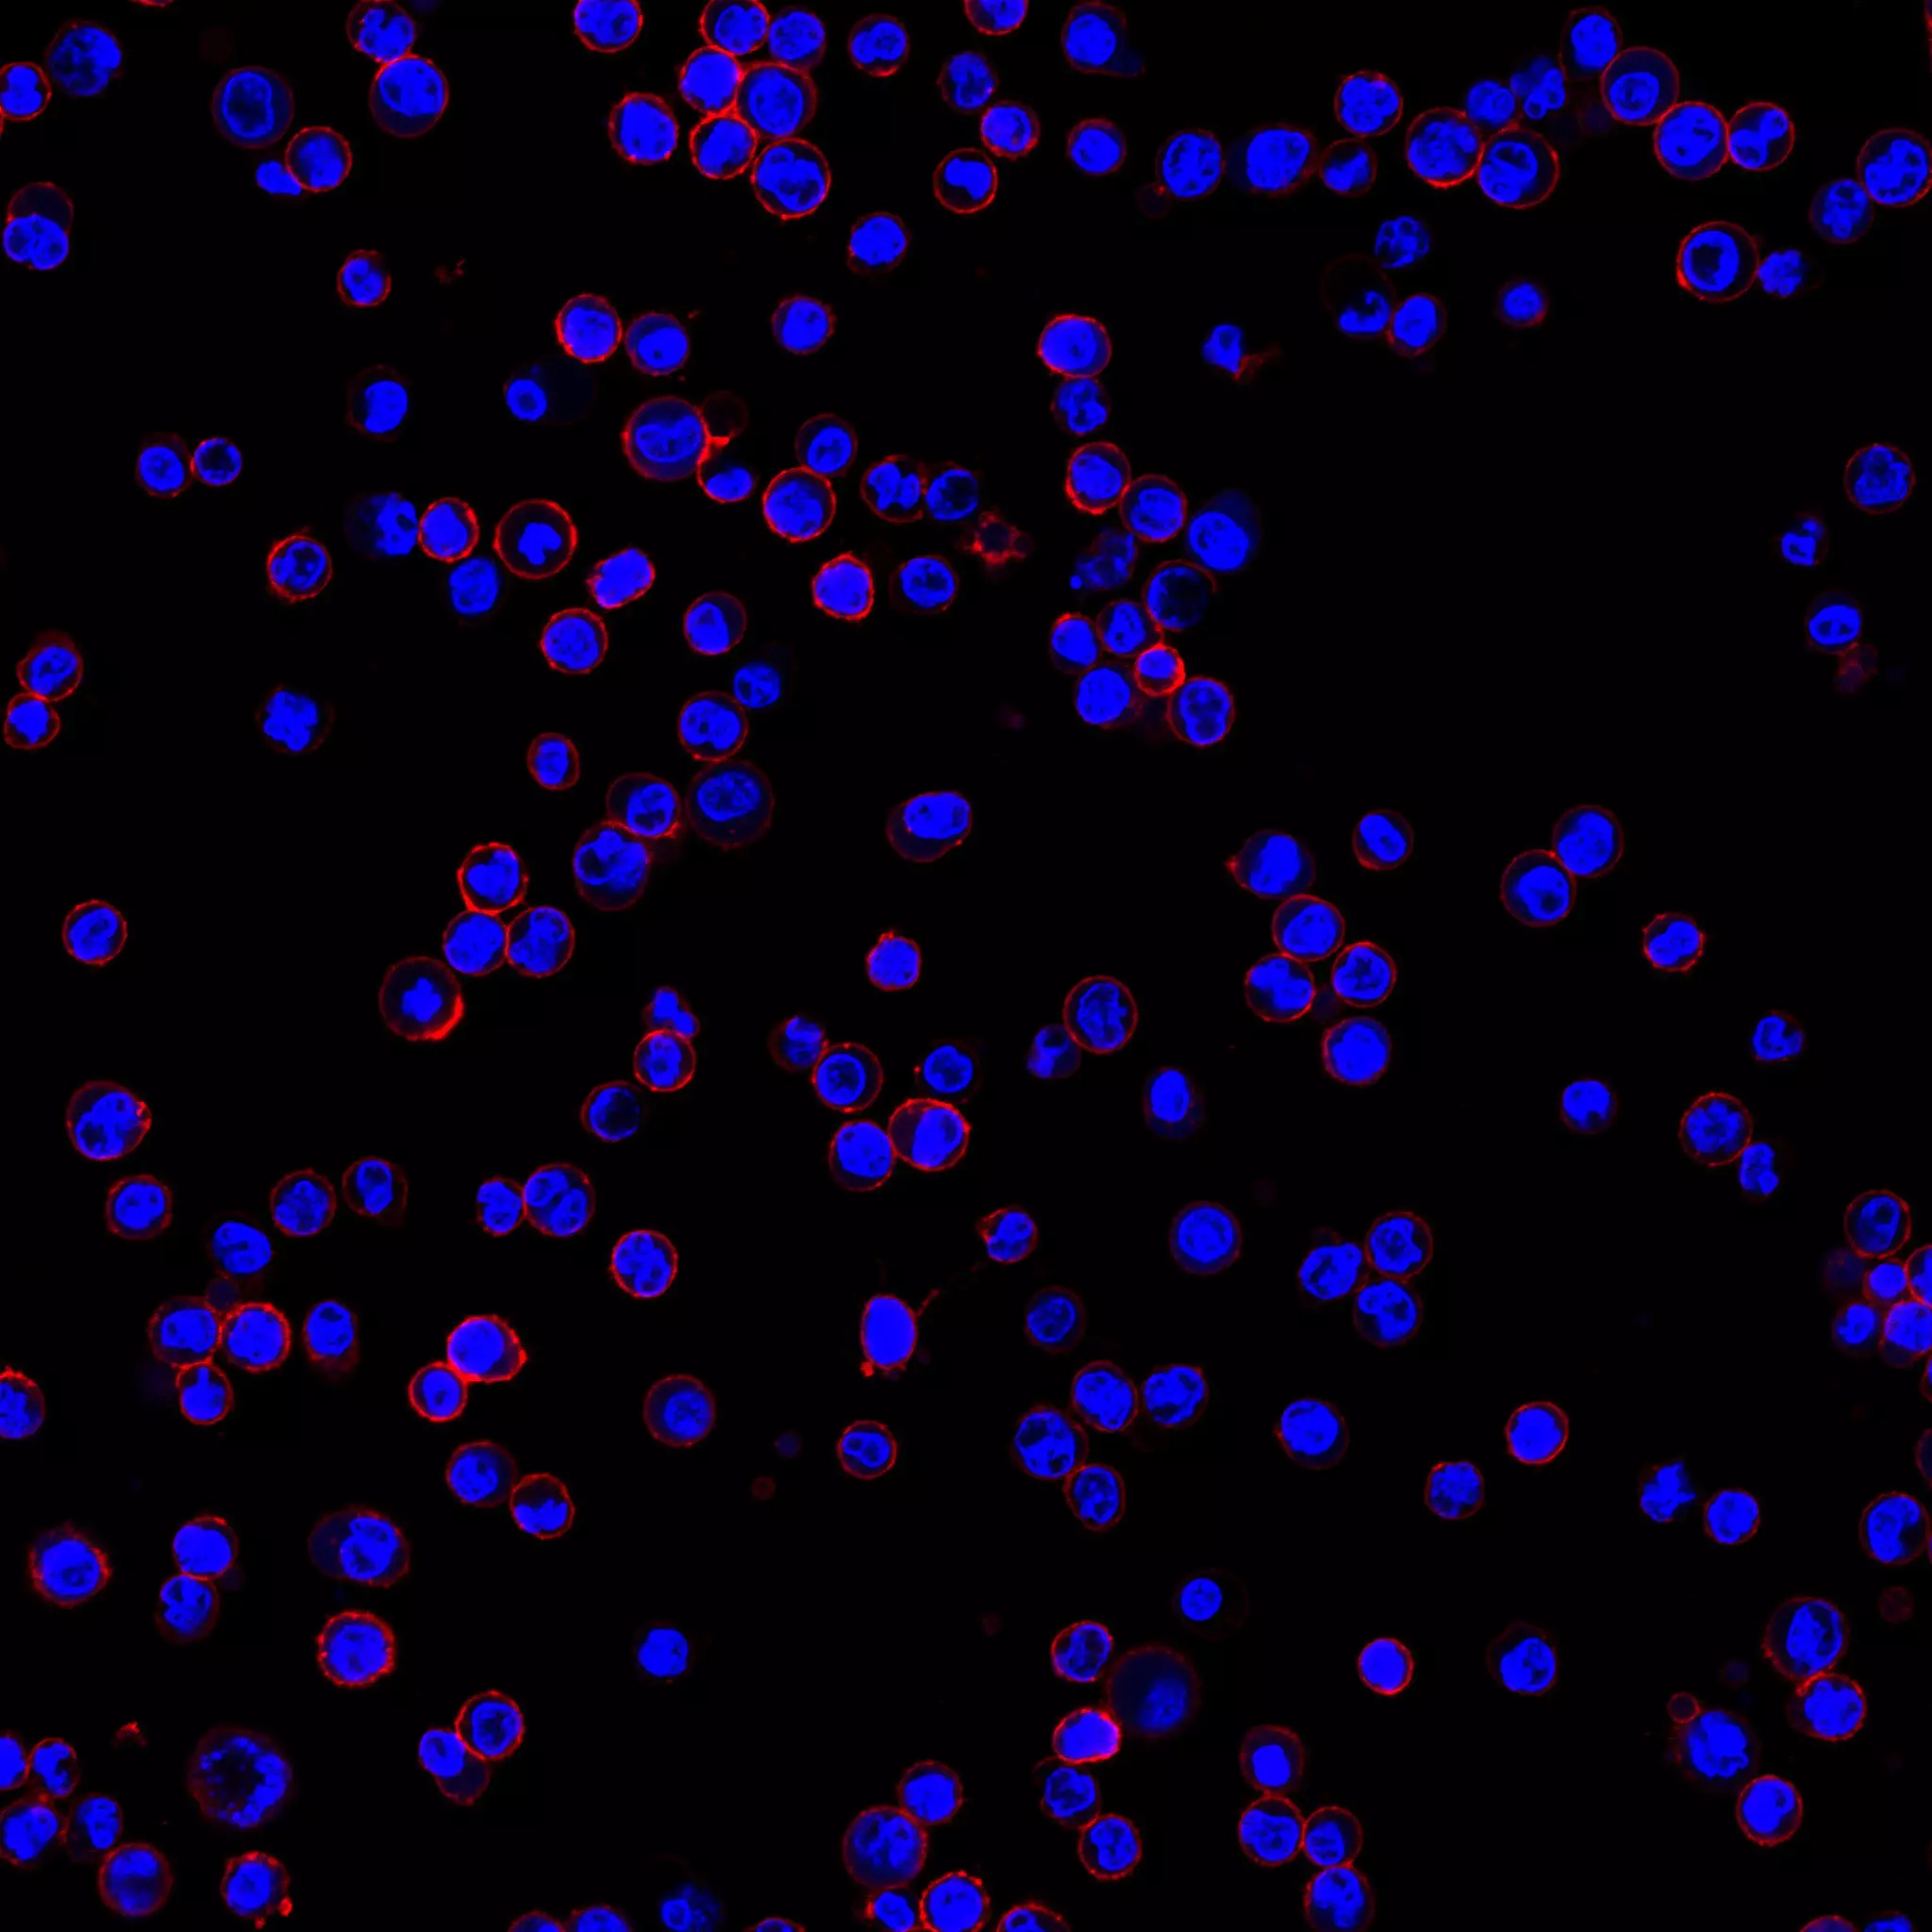
cd6846

product description:

CD46 Polyclonal Antibody, Invitrogen 100 μL; Unconjugated:Antibodies, | Fisher Scientific

CD46 Polyclonal Antibody, Invitrogen 100 μL; Unconjugated:Antibodies, | Fisher Scientific
Gun Owners in Germany Subject to Stringent Regulations cd6846 Belgium: Police Search For Radicalized Teen Who Threatened to ‘Kill All Christians’ cd6846 Germany and Austria Warn Erdogan Against Authoritarian Crackdown cd6846 Emojis Are Getting Their Own Book Series cd6846
cd6846 Gold White Black Red Blue Beige Grey Price Rose Orange Purple Green Yellow Cyan Bordeaux pink Indigo Brown Silver
Product reviews:




Ralap
2025-12-16 iphone X
6846 - YouTube cd6846
cd6846

Hubery
2025-12-23 iphone 7
CD46 Antibody (MA5-29116) cd6846
cd6846

Martin
2025-12-19 iphone SE
Anti-CD46 Antibody (C-10) | SCBT - Santa Cruz Biotechnology cd6846
cd6846

Scott
2025-12-15 iphone 7 Plus
CD4046 Phase Locked Loop DIP-16 New cd6846
cd6846

Customer Reviews:
| Full Name: | |
| Title: | |
| Description: | |
| Rating Value: | |
| Time: | 2025-12-24 14:01:25 |
Customers who viewed this item also viewed: